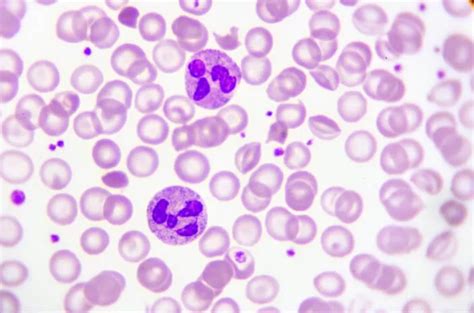

Bahasa Indonesianya Eagle: Kenali Lebih Dekat!
Bahasa Indonesianya Eagle: Kenali Lebih Dekat!
Guys , pernah gak sih kalian kepikiran, elang itu kalau di bahasa Indonesia-in jadi apa ya? Nah, di artikel ini, kita bakal bahas tuntas tentang bahasa Indonesianya eagle , plus fakta-fakta menarik lainnya tentang burung yang satu ini. Jadi, simak terus ya!
Table of Contents
Apa Bahasa Indonesianya Eagle?
Oke, langsung aja ya. Eagle dalam bahasa Indonesia adalah elang . Simpel, kan? Tapi, jangan salah, meskipun penyebutannya singkat, makna dan simbolisme yang terkandung di dalamnya sangatlah kaya. Elang sering kali diasosiasikan dengan kekuatan, keberanian, kebebasan, dan visi yang tajam. Gak heran kalau banyak negara dan organisasi yang menggunakan elang sebagai lambang atau simbol mereka. Elang juga sering muncul dalam berbagai mitos dan legenda di seluruh dunia, menambah kesan powerful dan majestic pada burung ini.
Elang, sebagai simbol kekuatan , telah lama digunakan dalam berbagai budaya dan peradaban. Dalam mitologi Yunani, elang adalah burung kesayangan Zeus, raja para dewa. Di Amerika Serikat, elang botak (bald eagle) adalah lambang negara yang melambangkan kebebasan dan kemerdekaan. Penggunaan elang sebagai simbol ini menunjukkan betapa besar kekaguman dan penghormatan manusia terhadap burung ini. Selain itu, elang juga sering dianggap sebagai simbol keberanian karena kemampuannya untuk terbang tinggi dan memangsa mangsanya dengan gagah berani. Kemampuan elang untuk berburu di ketinggian dan ketepatannya dalam menangkap mangsa menjadikannya inspirasi bagi banyak orang untuk berani menghadapi tantangan dan meraih tujuan. Tidak hanya itu, elang juga melambangkan kebebasan , karena burung ini dapat terbang ke mana pun ia suka tanpa terikat oleh batasan geografis. Kebebasan elang ini sering kali diartikan sebagai kebebasan berpikir, berbicara, dan bertindak. Elang juga dikenal memiliki visi yang tajam , yang memungkinkannya untuk melihat mangsanya dari jarak yang sangat jauh. Visi tajam elang ini sering kali dianalogikan dengan kemampuan untuk melihat peluang dan potensi yang tidak terlihat oleh orang lain. Dengan semua simbolisme yang melekat padanya, tidak mengherankan jika elang menjadi salah satu burung yang paling dihormati dan dikagumi di seluruh dunia.
Mengenal Lebih Dekat Berbagai Jenis Elang di Indonesia
Indonesia, sebagai negara dengan keanekaragaman hayati yang tinggi, juga menjadi rumah bagi berbagai jenis elang yang menakjubkan. Beberapa di antaranya bahkan merupakan spesies endemik alias hanya bisa ditemukan di Indonesia. Yuk, kita kenalan dengan beberapa jenis elang yang ada di Indonesia:
- Elang Jawa (Nisaetus bartelsi): Nah, kalau yang ini pasti udah pada tahu ya. Elang Jawa adalah maskot nasional Indonesia . Sayangnya, statusnya saat ini adalah terancam punah karena kehilangan habitat dan perburuan. Elang Jawa memiliki ciri khas berupa jambul di kepalanya yang membuatnya terlihat gagah. Elang Jawa bukan hanya sekadar burung, tetapi juga bagian penting dari identitas nasional Indonesia . Keberadaannya yang semakin terancam punah menjadi pengingat bagi kita semua untuk lebih peduli terhadap konservasi alam dan keanekaragaman hayati. Upaya pelestarian Elang Jawa melibatkan berbagai pihak, mulai dari pemerintah, organisasi non-pemerintah, hingga masyarakat lokal. Program-program konservasi yang dilakukan meliputi perlindungan habitat, penangkaran, dan edukasi kepada masyarakat tentang pentingnya menjaga kelestarian Elang Jawa. Selain itu, penegakan hukum terhadap pelaku perburuan dan perdagangan ilegal Elang Jawa juga menjadi kunci penting dalam upaya pelestarian ini. Dengan menjaga kelestarian Elang Jawa, kita tidak hanya melindungi spesies yang unik dan indah, tetapi juga menjaga warisan alam Indonesia yang tak ternilai harganya. Elang Jawa memiliki peran penting dalam menjaga keseimbangan ekosistem hutan di Jawa. Sebagai predator puncak, Elang Jawa membantu mengendalikan populasi hewan-hewan lain, seperti tikus dan ular, sehingga mencegah terjadinya ledakan populasi yang dapat merusak lingkungan. Kehadiran Elang Jawa juga menjadi indikator kesehatan hutan. Jika populasi Elang Jawa menurun, hal ini bisa menjadi pertanda bahwa ada masalah dengan kondisi hutan, seperti kerusakan habitat atau pencemaran lingkungan.
- Elang Flores (Nisaetus floris): Sesuai namanya, elang ini endemik Pulau Flores. Jumlahnya sangat sedikit dan statusnya juga terancam punah. Elang Flores memiliki ukuran tubuh yang relatif kecil dibandingkan jenis elang lainnya. Elang Flores, atau Nisaetus floris , adalah salah satu spesies elang paling langka dan terancam punah di dunia . Burung ini hanya dapat ditemukan di Pulau Flores, Nusa Tenggara Timur, Indonesia. Jumlah populasinya yang sangat sedikit menjadikannya prioritas utama dalam upaya konservasi. Keberadaan Elang Flores sangat penting bagi keanekaragaman hayati Indonesia dan kelangsungan ekosistem di Pulau Flores. Elang Flores menghadapi berbagai ancaman, termasuk hilangnya habitat akibat deforestasi, perburuan, dan perdagangan ilegal. Konversi hutan menjadi lahan pertanian dan perkebunan telah mengurangi area tempat tinggal dan sumber makanan Elang Flores. Selain itu, perburuan untuk diperdagangkan atau sekadar iseng juga menjadi ancaman serius bagi kelangsungan hidup spesies ini. Upaya konservasi Elang Flores melibatkan berbagai strategi, termasuk perlindungan habitat, penegakan hukum terhadap pelaku kejahatan lingkungan, dan peningkatan kesadaran masyarakat tentang pentingnya menjaga kelestarian Elang Flores. Pemerintah dan organisasi konservasi bekerja sama untuk melindungi hutan-hutan yang menjadi habitat Elang Flores dan mengembangkan program-program edukasi untuk masyarakat lokal. Partisipasi aktif dari masyarakat lokal sangat penting dalam upaya konservasi Elang Flores. Dengan memberikan pemahaman tentang manfaat menjaga kelestarian Elang Flores, diharapkan masyarakat dapat berperan serta dalam melindungi burung ini dan habitatnya. Selain itu, pengembangan ekowisata berbasis konservasi juga dapat memberikan insentif ekonomi bagi masyarakat lokal untuk menjaga kelestarian Elang Flores dan hutan-hutan di sekitarnya. Dengan upaya konservasi yang berkelanjutan, diharapkan populasi Elang Flores dapat meningkat dan spesies ini dapat terus menghiasi langit Pulau Flores.
- Elang Ular Bido (Spilornis cheela): Elang yang satu ini punya makanan favorit ular, sesuai dengan namanya. Elang Ular Bido tersebar luas di berbagai wilayah di Indonesia. Elang Ular Bido, atau Spilornis cheela , adalah salah satu jenis elang yang paling umum ditemukan di Indonesia . Burung ini memiliki kemampuan berburu ular yang sangat baik, sehingga sering disebut sebagai “elang ular”. Elang Ular Bido memainkan peran penting dalam mengendalikan populasi ular di berbagai ekosistem, sehingga menjaga keseimbangan alam. Elang Ular Bido memiliki ciri khas berupa bulu-bulu di sekitar matanya yang tampak seperti alis. Bulu-bulu ini melindungi mata elang dari gigitan ular saat berburu. Selain ular, Elang Ular Bido juga memangsa hewan-hewan lain, seperti kadal, burung kecil, dan mamalia kecil. Elang Ular Bido tersebar luas di berbagai wilayah di Indonesia, mulai dari Sumatera, Jawa, Kalimantan, Sulawesi, hingga Papua. Burung ini dapat ditemukan di berbagai jenis habitat, seperti hutan, perkebunan, dan lahan pertanian. Meskipun populasinya masih relatif stabil, Elang Ular Bido tetap menghadapi ancaman seperti hilangnya habitat akibat deforestasi dan perburuan. Oleh karena itu, upaya konservasi tetap diperlukan untuk menjaga kelestarian spesies ini. Upaya konservasi Elang Ular Bido dapat dilakukan dengan melindungi habitat alaminya, mencegah perburuan, dan meningkatkan kesadaran masyarakat tentang pentingnya menjaga kelestarian elang ular dan peranannya dalam ekosistem. Dengan menjaga kelestarian Elang Ular Bido, kita juga turut menjaga keseimbangan alam dan keanekaragaman hayati Indonesia.
Fakta-Fakta Menarik Seputar Elang
Selain jenis-jenisnya, ada banyak fakta menarik tentang elang yang sayang untuk dilewatkan. Berikut beberapa di antaranya:
- Penglihatan yang Tajam: Elang terkenal dengan penglihatannya yang sangat tajam. Mereka bisa melihat mangsa dari jarak yang sangat jauh, bahkan beberapa kilometer. Penglihatan elang yang tajam adalah hasil evolusi yang memungkinkannya untuk berburu dengan efektif . Mata elang memiliki lebih banyak sel kerucut dibandingkan manusia, yang memungkinkan mereka untuk melihat warna dengan lebih jelas dan membedakan detail-detail kecil dari jarak jauh. Selain itu, elang juga memiliki kemampuan untuk memperbesar gambar, seperti menggunakan teropong, sehingga mereka dapat melihat mangsa dengan lebih jelas. Kemampuan penglihatan yang luar biasa ini menjadikan elang sebagai salah satu predator paling sukses di dunia . Elang dapat menggunakan penglihatannya untuk mencari mangsa di berbagai jenis habitat, mulai dari hutan, padang rumput, hingga pegunungan. Mereka dapat melihat mangsa yang bersembunyi di balik dedaunan atau di bawah permukaan air. Penglihatan elang yang tajam juga membantu mereka untuk menghindari bahaya, seperti predator lain atau rintangan saat terbang. Dengan penglihatan yang tajam, elang dapat dengan mudah menemukan jalan pulang ke sarangnya, bahkan setelah terbang jauh untuk berburu. Penglihatan elang yang luar biasa ini adalah salah satu adaptasi yang paling mengesankan di dunia hewan.
- Kemampuan Terbang yang Luar Biasa: Elang adalah penerbang yang handal. Mereka bisa terbang tinggi, melayang-layang di udara, dan menukik dengan kecepatan tinggi untuk menangkap mangsa. Kemampuan terbang elang yang luar biasa adalah hasil dari kombinasi faktor fisik dan perilaku . Elang memiliki sayap yang lebar dan kuat, yang memungkinkannya untuk menghasilkan daya angkat yang cukup untuk terbang tinggi dan melayang-layang di udara. Selain itu, elang juga memiliki tulang yang ringan dan otot yang kuat, yang memungkinkannya untuk terbang dengan efisien dan hemat energi. Elang juga memiliki kemampuan untuk memanfaatkan arus udara panas (thermal) untuk terbang tinggi tanpa harus mengepakkan sayapnya. Kemampuan ini memungkinkan elang untuk menghemat energi dan terbang jarak jauh dengan mudah. Selain itu, elang juga memiliki kemampuan untuk menukik dengan kecepatan tinggi untuk menangkap mangsa. Saat menukik, elang dapat mencapai kecepatan hingga 300 kilometer per jam, menjadikannya salah satu hewan tercepat di dunia . Kemampuan terbang elang yang luar biasa memungkinkan mereka untuk berburu di berbagai jenis habitat dan menangkap mangsa yang sulit dijangkau oleh hewan lain. Elang dapat terbang di atas hutan, padang rumput, dan pegunungan untuk mencari mangsa. Mereka juga dapat terbang di dekat permukaan air untuk menangkap ikan. Kemampuan terbang elang yang luar biasa adalah salah satu adaptasi yang paling mengesankan di dunia hewan.
- Umur yang Panjang: Beberapa jenis elang bisa hidup hingga puluhan tahun di alam liar. Umur panjang ini memungkinkan mereka untuk menghasilkan banyak keturunan selama hidupnya. Umur panjang elang adalah hasil dari kombinasi faktor genetik dan lingkungan . Elang memiliki sistem kekebalan tubuh yang kuat, yang membantu mereka untuk melawan penyakit dan infeksi. Selain itu, elang juga memiliki kemampuan untuk memperbaiki sel-sel tubuh yang rusak, sehingga memperlambat proses penuaan. Lingkungan tempat elang hidup juga memainkan peran penting dalam menentukan umur mereka. Elang yang hidup di lingkungan yang bersih dan memiliki banyak sumber makanan cenderung memiliki umur yang lebih panjang dibandingkan elang yang hidup di lingkungan yang tercemar atau kekurangan makanan. Umur panjang elang memungkinkan mereka untuk menghasilkan banyak keturunan selama hidupnya . Elang betina biasanya hanya menghasilkan satu atau dua telur setiap tahun. Namun, karena mereka dapat hidup hingga puluhan tahun, mereka dapat menghasilkan puluhan anak elang selama hidupnya. Umur panjang elang juga memungkinkan mereka untuk belajar dan beradaptasi dengan perubahan lingkungan. Elang yang lebih tua memiliki pengalaman yang lebih banyak dalam berburu dan menghindari bahaya, sehingga mereka lebih mungkin untuk bertahan hidup dan menghasilkan keturunan. Umur panjang elang adalah salah satu faktor yang berkontribusi terhadap keberhasilan mereka sebagai predator puncak.
Kesimpulan
Nah, sekarang guys udah tahu kan, bahasa Indonesianya eagle itu adalah elang . Selain itu, kita juga udah kenalan dengan berbagai jenis elang yang ada di Indonesia dan fakta-fakta menarik lainnya. Semoga artikel ini bermanfaat dan menambah wawasan kalian ya! Jangan lupa untuk terus menjaga kelestarian elang dan habitatnya agar burung-burung gagah ini tetap bisa kita saksikan di langit Indonesia.